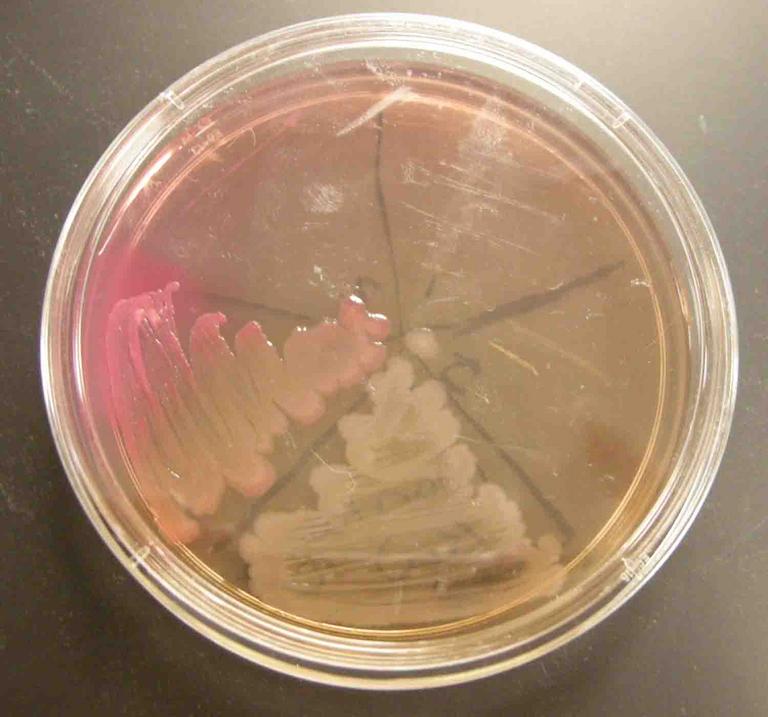

| ||||
Bacterial Growth Media & Cultures
Laboratory Exercise
Lab #4: Bacterial Growth Media & Cultures Lab
This is the main page for the Media & Culture Laboratory Topic of an 8-week introductory college microbiology class. The following links will take you to the Virtual Microbiology Classroom documents that you will need to prepare for lab.
SPO VIRTUAL CLASSROOMS
 | ||||||
ADDITIONAL LABORATORY REQUIRED READINGS
Here is what you need to read, in addition to the PowerPoint and Lab Exercise Instructions & Report, to master this topic.
Aseptic Technique
Bacterial Colony Morphology
Bacterial Growth Media
- Differential & Selective Bacterial Growth Media: MacConkey's, Mannitol Salt & Blood Agar
- Cellular Metabolism: What Is Fermentation?
BACTERIAL MEDIA & CULTURES HELPFUL LINKS
The following are useful links to additional online materials that may help students better understand this laboratory exercise.
- Aseptic Technique and the Transfer of Microorganisms from Amrita Laboratories
- Bacterial growth video and narration, YouTube, Dizzo95.
- Microbial Growth & Metabolism Main Page on the Virtual Microbiology Classroom of Science Prof Online.
- Germs - song by Weird Al Yankovic
BACTERIAL MEDIA & CULTURES LAB IMAGES
The images linked here directly relate to the lab exercise and are designed to help students review and study that lab material while outside of lab.
NOTE: Students must review all material in categories highlighted with red titles PRIOR TO ATTENDING LAB in order to be prepared to participate.
BACTERIAL MEDIA & CULTURES LAB DOCS
The Lab Exercise Instructions are the main resource required for students to understand and complete this exercise. They provide a thorough explanation of the lab topic, as well as detailed directions on how to complete the exercise. The Lab Report Assignment is the homework that students complete and turn in.
- Lab #4: Bacterial Growth Media & Cultures Lab Exercise INSTRUCTIONS
- Lab #4: Bacterial Growth Media & Cultures Lab Report ASSIGNMENT
BACTERIAL GROWTH MEDIA & CULTURES LAB POWERPOINTS
The Lab PowerPoints used to introduce the material in the related Lab Exercise Instructions & Report Assignment.
- Lab #4: Bacterial Media & Cultures Lab PPT Show
- Lab #4: Bacterial Media & Cultures Lab PowerPoint PDF Printout
Printing: The best way for students to print out the PowerPoint Show is to download the PDF version. Select Print, and, when the Print screen comes up, go to the Print Handling options. Under Page Scaling, select "Multiple pages per sheet", Under Pages per sheet, select "2". That uses up less paper, placing two slides on each page.
SCIENCE PHOTOS
How to Light a Bunsen Burner
(Put your goggles on first!)
How to Pour TSY Media Into Petri Dishes
(Put your goggles on first!)
How to Interpret MacConkey's Agar (MAC) Specialized
Bacterial Growth Medium
How to Interpret Mannitol Salt Agar (MSA) Specialized
Bacterial Growth Medium
How to Interpret Blood Agar (BAP) Specialized Bacterial Growth Medium
MacConkey's Agar Quiz & Review: Do you know MAC from shinola?
BACTERIAL MEDIA & CULTURE LAB VIDEOS
- Lab Exercise & Report Word documents
- Laboratory PowerPoint
- Additional lab required readings
- Videos on interpreting specialized bacterial growth media
- Related images
- Additional articles and links that support the lecture material
SCIENCE VIDEOS
Page last updated: 2/2016
You have free access to a large collection of materials used in a college-level introductory microbiology course. The Virtual Microbiology Classroom provides a wide range of free educational resources including PowerPoint Lectures, Study Guides, Review Questions and Practice Test Questions.
The following links will take you to the Virtual Microbiology Classroom documents that you will need to prepare for lab.
The Media & Culture Lab materials include:
TSY, MacConkey's and
Mannitol Salt Agars (top to bottom) inoculated with bacterial control pinwheels. From top right section counter clockwise:
1. Staph epidermidis, 2. Staph aureus, 3. E. coli, 4. Salmonella pullorum,
5. negative control
Back to >